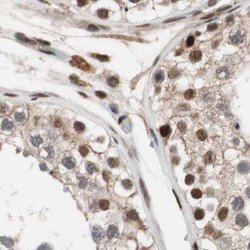
Invitrogen CHAMP1 Polyclonal Antibody 100 &mu;L; Unconjugated:Antibodies,

missing translation for 'onlineSavingsMsg'
Learn More
Learn More
Invitrogen™ CHAMP1 Polyclonal Antibody


Rabbit Polyclonal Antibody
Brand: Invitrogen™ PA552313
This item is not returnable.
View return policy
Description
Immunogen sequence: YYHITSKHAS PDKWNDKPKN QLNKETDPVK SPPLPEHQKI PCNSAEPKSI PALSMETQKL GSVLSPESPK PTPLTPLEPQ KPGSVVSPEL QTPLPSPEPS KPASVSSPEP P Highest antigen sequence identity to the following orthologs: Mouse - 47%, Rat - 51%.
Required for proper alignment of chromosomes at metaphase and their accurate segregation during mitosis. Involved in the maintenance of spindle microtubules attachment to the kinetochore during sister chromatid biorientation. May recruit CENPE and CENPF to the kinetochore.
Specifications
| CHAMP1 | |
| Polyclonal | |
| Unconjugated | |
| CHAMP1 | |
| AA675043; AI116001; C13orf8; CAMP; CHAMP; Champ1; chromosome alignment maintaining phosphoprotein 1; chromosome alignment-maintaining phosphoprotein 1; D8Ertd457e; D8Ertd569e; Kiaa1802; mKIAA1802; MRD40; RGD1311283; Zfp828; zinc finger protein 828; ZNF828 | |
| Rabbit | |
| Antigen affinity chromatography | |
| RUO | |
| 283489 | |
| Store at 4°C short term. For long term storage, store at -20°C, avoiding freeze/thaw cycles. | |
| Liquid |
| Immunohistochemistry (Paraffin), Western Blot, Immunocytochemistry | |
| 0.20 mg/mL | |
| PBS with 40% glycerol and 0.02% sodium azide; pH 7.2 | |
| Q96JM3 | |
| CHAMP1 | |
| Recombinant protein corresponding to Human CHAMP1. Recombinant protein control fragment (Product #RP-89501). | |
| 100 μL | |
| Primary | |
| Human | |
| Antibody | |
| IgG |
Product Content Correction
Your input is important to us. Please complete this form to provide feedback related to the content on this product.
Product Title
Spot an opportunity for improvement?Share a Content Correction